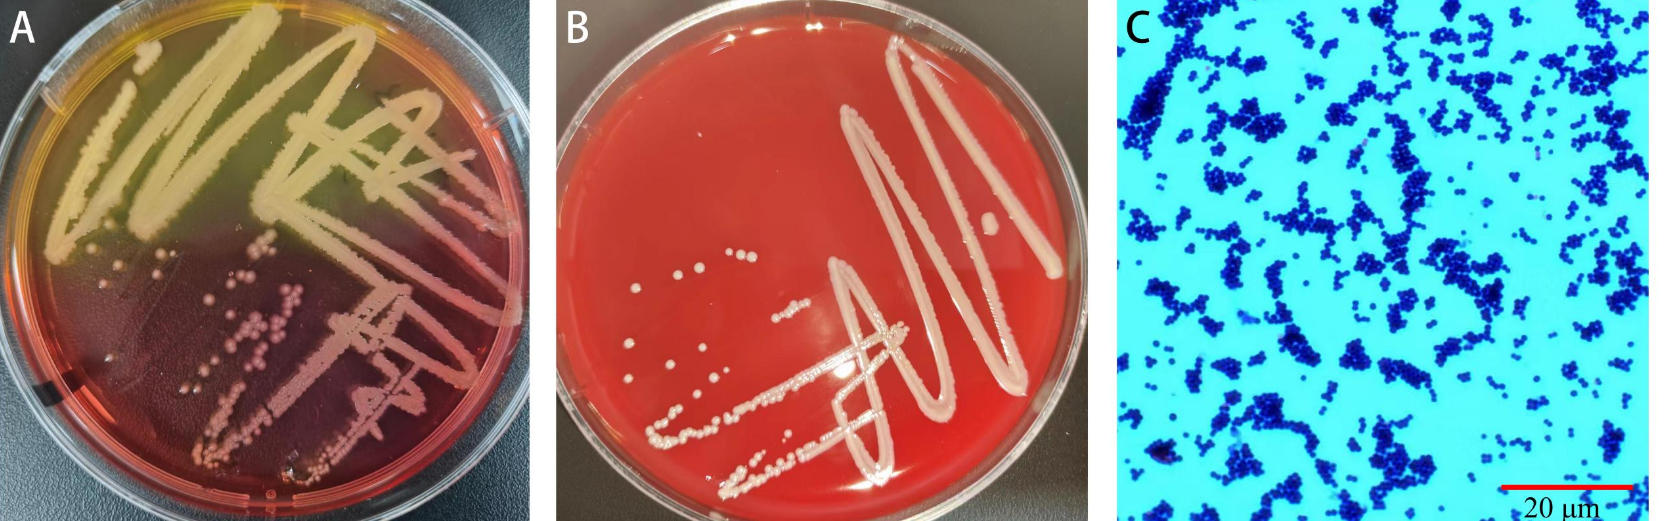

鳞状皮屑裸小鼠木糖葡萄球菌的分离鉴定
Isolation and Identification of Staphylococcus xylosus in Nude Mice with Squamous Skin Scurfs

鳞状皮屑裸小鼠木糖葡萄球菌的分离鉴定 |
| 孔志豪, 魏晓锋, 于灵芝, 冯丽萍, 朱琦, 施国君, 王晨 |
|
Isolation and Identification of Staphylococcus xylosus in Nude Mice with Squamous Skin Scurfs |
| KONG Zhihao, WEI Xiaofeng, YU Lingzhi, FENG Liping, ZHU Qi, SHI Guojun, WANG Chen |
| 图2 分离菌株在高盐甘露醇琼脂平板(A)和血琼脂平板(B)上的菌落形态图以及革兰染色镜检图(C) |
| Figure 2 Colony morphology on mannitol salt agar plate (A) and blood agar plate (B) and Gram staining microscopic examination (C) of the isolated strain |
|